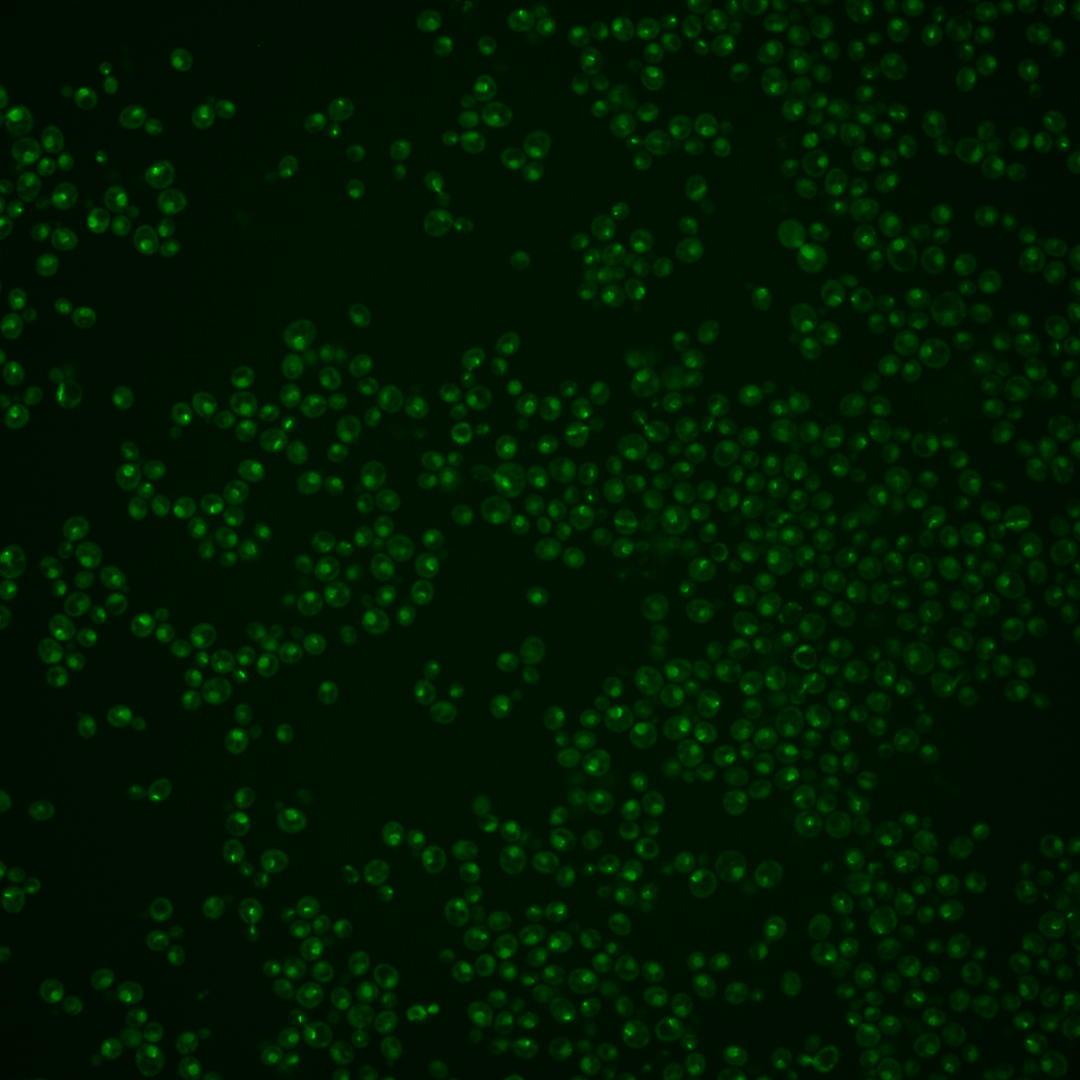
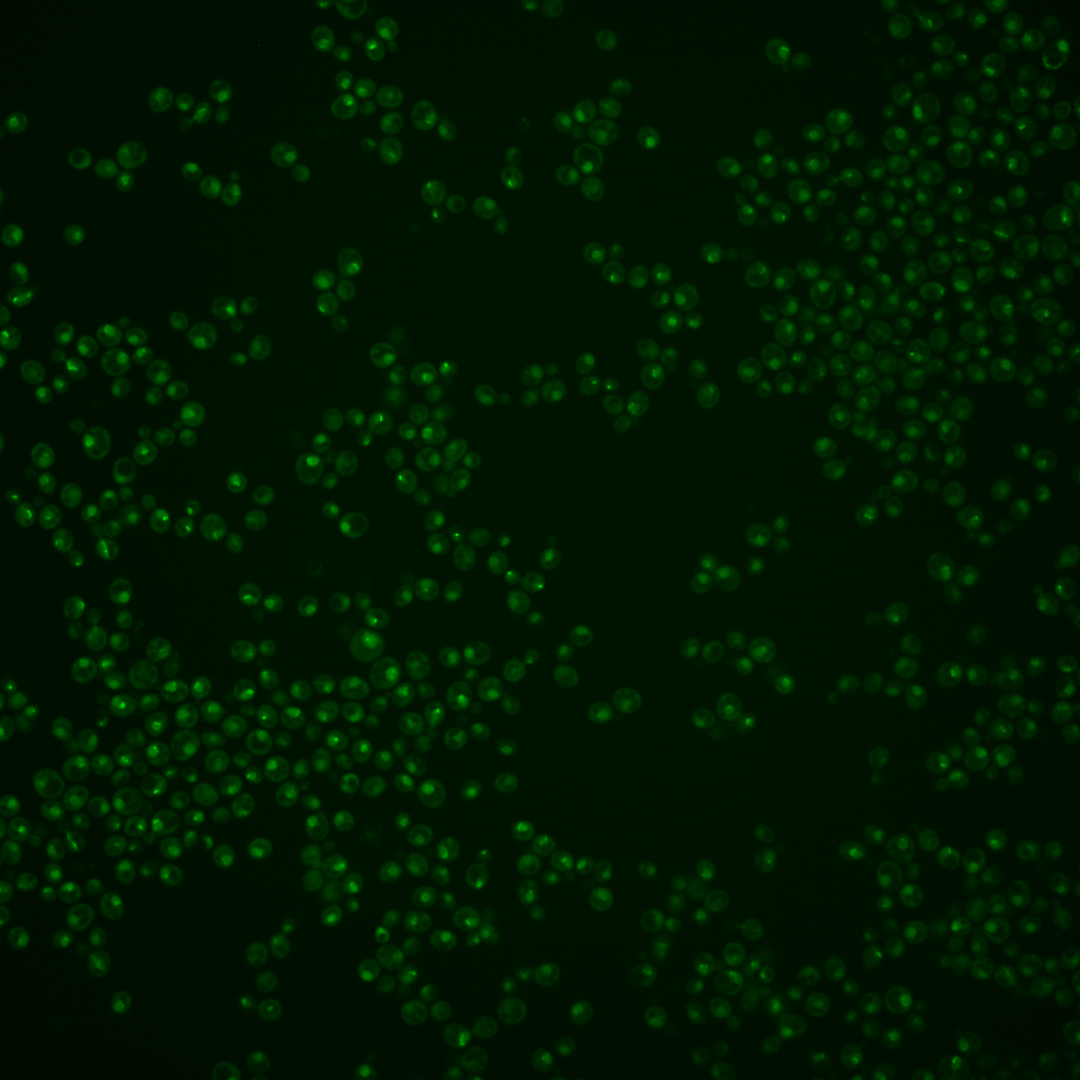

| Standard name | |
|---|---|
| Human Ortholog | |
| Description | Subunit of the condensin complex; required for establishment and maintenance of chromosome condensation, chromosome segregation, chromatin binding of condensin, tRNA gene clustering at the nucleolus, and silencing at the mating type locus; required for replication slow zone (RSZ) breakage following Mec1p inactivation |
Micrographs




















































































Sub-cellular Localization
Yeast GFP Assignment
Protein Abundance
Localization Change
External localization resources
| ensLOC | DeepLoc | |||||||||||||||||||||||
|---|---|---|---|---|---|---|---|---|---|---|---|---|---|---|---|---|---|---|---|---|---|---|---|---|
| Localization | WT1 | WT2 | WT3 | RAP60 | RAP140 | RAP220 | RAP300 | RAP380 | RAP460 | RAP540 | RAP620 | RAP700 | HU80 | HU120 | HU160 | rpd3Δ_1 | rpd3Δ_2 | rpd3Δ_3 | WT1 | WT2 | WT3 | AF100 | AF140 | AF180 |
| Cortical Patches | 0 | 0 | 0 | 0 | 0 | 0 | 0 | 0 | 0 | 0 | 0 | 0 | 0 | 0 | 0 | 0 | 0 | 0 | 2 | 0 | 0 | 0 | 1 | 2 |
| Bud | 2 | 0 | 3 | 7 | 5 | 8 | 16 | 15 | 14 | 18 | 7 | 13 | 0 | 1 | 2 | 0 | 0 | 0 | 4 | 0 | 2 | 0 | 4 | 2 |
| Bud Neck | 0 | 0 | 0 | 1 | 2 | 4 | 3 | 4 | 0 | 0 | 1 | 1 | 0 | 0 | 0 | 0 | 0 | 0 | 1 | 2 | 1 | 0 | 1 | 2 |
| Bud Site | 3 | 1 | 5 | 7 | 14 | 16 | 24 | 27 | 17 | 23 | 13 | 16 | 0 | 0 | 0 | 0 | 1 | 0 | – | – | – | – | – | – |
| Cell Periphery | 1 | 0 | 0 | 0 | 0 | 0 | 0 | 0 | 0 | 0 | 0 | 0 | 0 | 0 | 0 | 1 | 0 | 1 | 0 | 0 | 0 | 0 | 0 | 0 |
| Cytoplasm | 8 | 3 | 5 | 9 | 9 | 23 | 28 | 29 | 30 | 32 | 13 | 17 | 17 | 23 | 34 | 16 | 12 | 11 | 2 | 1 | 0 | 0 | 1 | 4 |
| Endoplasmic Reticulum | 0 | 0 | 0 | 2 | 1 | 0 | 0 | 0 | 0 | 0 | 0 | 1 | 0 | 0 | 0 | 1 | 2 | 2 | 1 | 0 | 0 | 0 | 0 | 1 |
| Endosome | 21 | 1 | 1 | 0 | 9 | 4 | 1 | 3 | 3 | 1 | 0 | 1 | 2 | 3 | 2 | 8 | 9 | 15 | 46 | 6 | 20 | 14 | 28 | 47 |
| Golgi | 0 | 0 | 0 | 0 | 0 | 0 | 0 | 0 | 0 | 0 | 0 | 0 | 0 | 0 | 0 | 2 | 2 | 2 | 2 | 0 | 0 | 0 | 0 | 2 |
| Mitochondria | 19 | 23 | 133 | 161 | 151 | 269 | 334 | 363 | 282 | 368 | 173 | 308 | 15 | 15 | 54 | 9 | 6 | 16 | 6 | 1 | 4 | 0 | 6 | 13 |
| Nucleus | 293 | 67 | 117 | 159 | 128 | 153 | 175 | 238 | 122 | 213 | 99 | 146 | 142 | 166 | 150 | 95 | 73 | 52 | 207 | 78 | 90 | 47 | 61 | 38 |
| Nuclear Periphery | 19 | 5 | 2 | 1 | 4 | 3 | 7 | 4 | 6 | 10 | 6 | 9 | 3 | 3 | 4 | 4 | 2 | 2 | 25 | 1 | 10 | 0 | 1 | 7 |
| Nucleolus | 143 | 16 | 36 | 48 | 73 | 78 | 104 | 91 | 73 | 104 | 37 | 68 | 20 | 35 | 46 | 33 | 43 | 62 | 133 | 15 | 35 | 29 | 39 | 31 |
| Peroxisomes | 2 | 0 | 0 | 0 | 0 | 0 | 0 | 1 | 0 | 2 | 1 | 0 | 0 | 0 | 0 | 0 | 0 | 0 | 0 | 0 | 0 | 0 | 1 | 0 |
| SpindlePole | 33 | 0 | 15 | 25 | 49 | 56 | 64 | 61 | 14 | 28 | 8 | 30 | 0 | 1 | 5 | 7 | 15 | 16 | 66 | 6 | 26 | 15 | 23 | 44 |
| Vac/Vac Membrane | 9 | 9 | 1 | 1 | 5 | 5 | 4 | 2 | 6 | 2 | 4 | 3 | 6 | 4 | 8 | 9 | 9 | 5 | 19 | 6 | 14 | 8 | 34 | 43 |
| Unique Cell Count | 465 | 99 | 196 | 264 | 312 | 398 | 499 | 538 | 377 | 509 | 227 | 394 | 184 | 227 | 249 | 154 | 148 | 138 | 535 | 123 | 211 | 121 | 211 | 254 |
| Labelled Cell Count | 553 | 125 | 318 | 421 | 450 | 619 | 760 | 838 | 567 | 801 | 362 | 613 | 205 | 251 | 305 | 185 | 174 | 184 | 535 | 123 | 211 | 121 | 211 | 254 |
Yeast GFP Assignment
Protein Abundance
| Screen | WT1 | WT2 | WT3 | RAP60 | RAP140 | RAP220 | RAP300 | RAP380 | RAP460 | RAP540 | RAP620 | RAP700 | HU80 | HU120 | HU160 | rpd3Δ_1 | rpd3Δ_2 | rpd3Δ_3 | AF100 | AF140 | AF180 |
|---|---|---|---|---|---|---|---|---|---|---|---|---|---|---|---|---|---|---|---|---|---|
| Mean Cell GFP Intensity (1e-4) | 6.4 | 4.8 | 3.8 | 3.8 | 4.0 | 3.5 | 3.4 | 3.6 | 3.1 | 3.2 | 3.1 | 2.9 | 5.8 | 5.7 | 4.8 | 8.3 | 8.8 | 8.9 | 5.4 | 5.2 | 6.1 |
| Std Deviation (1e-4) | 0.9 | 1.5 | 0.7 | 1.0 | 1.1 | 0.8 | 0.9 | 1.1 | 1.1 | 1.2 | 1.0 | 1.0 | 1.7 | 1.3 | 1.3 | 2.0 | 2.2 | 2.1 | 1.4 | 1.1 | 2.1 |
| Intensity Change (Log2) | – | – | – | -0.0 | 0.07 | -0.12 | -0.16 | -0.1 | -0.27 | -0.23 | -0.28 | -0.39 | 0.61 | 0.59 | 0.35 | 1.12 | 1.21 | 1.23 | 0.51 | 0.47 | 0.69 |
Localization Change
| Localization | RAP60 | RAP140 | RAP220 | RAP300 | RAP380 | RAP460 | RAP540 | RAP620 | RAP700 | HU80 | HU120 | HU160 | rpd3Δ_1 | rpd3Δ_2 | rpd3Δ_3 |
|---|---|---|---|---|---|---|---|---|---|---|---|---|---|---|---|
| Actin | – | – | – | – | – | – | – | – | – | – | – | – | – | – | – |
| Bud | – | – | – | – | – | – | – | – | – | – | – | – | – | – | – |
| Bud Neck | – | – | – | – | – | – | – | – | – | – | – | – | – | – | – |
| Bud Site | – | – | – | – | – | – | – | – | – | – | – | – | – | – | – |
| Cell Periphery | – | – | – | – | – | – | – | – | – | – | – | – | – | – | – |
| Cyto | – | – | – | – | – | – | – | – | – | – | – | – | – | – | – |
| Endoplasmic Reticulum | – | – | – | – | – | – | – | – | – | – | – | – | – | – | – |
| Endosome | – | – | – | – | – | – | – | – | – | – | – | – | – | – | – |
| Golgi | – | – | – | – | – | – | – | – | – | – | – | – | – | – | – |
| Mitochondria | – | – | – | – | – | – | – | – | – | – | – | – | – | – | – |
| Nuclear Periphery | – | – | – | – | – | – | – | – | – | – | – | – | – | – | – |
| Nuc | – | – | – | – | – | – | – | – | – | – | – | – | – | – | – |
| Nucleolus | – | – | – | – | – | – | – | – | – | – | – | – | – | – | – |
| Peroxisomes | – | – | – | – | – | – | – | – | – | – | – | – | – | – | – |
| SpindlePole | – | – | – | – | – | – | – | – | – | – | – | – | – | – | – |
| Vac | – | – | – | – | – | – | – | – | – | – | – | – | – | – | – |
| Cortical Patches | – | – | – | – | – | – | – | – | – | – | – | – | – | – | – |
| Cytoplasm | – | – | – | – | – | – | – | – | – | – | – | – | – | – | – |
| Nucleus | – | – | – | – | – | – | – | – | – | – | – | – | – | – | – |
| Vacuole | – | – | – | – | – | – | – | – | – | – | – | – | – | – | – |
External localization resources
Images






























Protein Concentration and Protein Localization Data
| R1 | R2 | R3 | ||||||||||||||||
|---|---|---|---|---|---|---|---|---|---|---|---|---|---|---|---|---|---|---|
| G1 Pre-START | G1 Post-START | S/G2 | Metaphase | Anaphase | Telophase | G1 Pre-START | G1 Post-START | S/G2 | Metaphase | Anaphase | Telophase | G1 Pre-START | G1 Post-START | S/G2 | Metaphase | Anaphase | Telophase | |
| Concentration | 0.8407 | 0.9471 | 1.1426 | 1.0642 | 0.6149 | 1.0407 | 2.0196 | 2.3106 | 2.5171 | 2.0349 | 2.6575 | 2.4438 | 1.2606 | 1.3137 | 1.2597 | 1.3541 | 1.1142 | 1.3024 |
| Actin | 0.0002 | 0.0005 | 0.0003 | 0.0007 | 0.0025 | 0.0004 | 0.0055 | 0.0003 | 0.0075 | 0.0001 | 0.0065 | 0.0068 | 0.0175 | 0.0003 | 0.0003 | 0.0005 | 0.0001 | 0.0005 |
| Bud | 0 | 0.0002 | 0.0001 | 0.0003 | 0.0003 | 0.0002 | 0.0003 | 0.0002 | 0.0014 | 0.0001 | 0.0003 | 0.0003 | 0.0001 | 0.0001 | 0.0001 | 0.0001 | 0.0001 | 0.0001 |
| Bud Neck | 0.0011 | 0.0022 | 0.0025 | 0.0106 | 0.2169 | 0.0074 | 0.0012 | 0.0023 | 0.0022 | 0.0032 | 0.0025 | 0.0061 | 0.0009 | 0.0016 | 0.0019 | 0.0024 | 0.0249 | 0.0044 |
| Bud Periphery | 0.0001 | 0.0003 | 0.0003 | 0.0013 | 0.0008 | 0.0005 | 0.0005 | 0.0004 | 0.0024 | 0.0002 | 0.001 | 0.0008 | 0.0003 | 0.0003 | 0.0002 | 0.0003 | 0.0002 | 0.0005 |
| Bud Site | 0.0003 | 0.0032 | 0.0015 | 0.0018 | 0.0037 | 0.0007 | 0.0023 | 0.0014 | 0.0132 | 0.0007 | 0.001 | 0.0008 | 0.0007 | 0.0018 | 0.0009 | 0.001 | 0.0009 | 0.0003 |
| Cell Periphery | 0.0001 | 0.0002 | 0.0002 | 0.0005 | 0.0005 | 0.0001 | 0.0001 | 0.0002 | 0.0003 | 0.0002 | 0.0002 | 0.0001 | 0.0001 | 0.0002 | 0.0002 | 0.0002 | 0.0003 | 0.0003 |
| Cytoplasm | 0.0075 | 0.009 | 0.0046 | 0.0004 | 0.0006 | 0.0018 | 0.007 | 0.0043 | 0.0019 | 0.0001 | 0.0128 | 0.0014 | 0.0026 | 0.0125 | 0.0013 | 0.0005 | 0.0002 | 0.0028 |
| Cytoplasmic Foci | 0.0005 | 0.0005 | 0.002 | 0.0026 | 0.0105 | 0.0009 | 0.0169 | 0.0022 | 0.0197 | 0.0062 | 0.0176 | 0.0023 | 0.0052 | 0.0032 | 0.0017 | 0.0125 | 0.0037 | 0.003 |
| Eisosomes | 0 | 0 | 0 | 0.0001 | 0.0002 | 0.0001 | 0.0001 | 0 | 0.0001 | 0 | 0.0002 | 0.0001 | 0.0003 | 0.0001 | 0.0001 | 0.0001 | 0 | 0.0001 |
| Endoplasmic Reticulum | 0.0007 | 0.002 | 0.0012 | 0.0009 | 0.0002 | 0.0003 | 0.0018 | 0.0006 | 0.003 | 0 | 0.0028 | 0.0056 | 0.0007 | 0.0016 | 0.0003 | 0.0004 | 0 | 0.0002 |
| Endosome | 0.0021 | 0.0023 | 0.0034 | 0.0017 | 0.0051 | 0.0011 | 0.017 | 0.0024 | 0.0117 | 0.0008 | 0.0279 | 0.0128 | 0.0077 | 0.0067 | 0.002 | 0.0078 | 0.0012 | 0.0017 |
| Golgi | 0.0001 | 0.0002 | 0.0005 | 0.0007 | 0.0037 | 0.0002 | 0.0042 | 0.0006 | 0.006 | 0.0008 | 0.0167 | 0.0062 | 0.0039 | 0.0007 | 0.0005 | 0.0046 | 0.0009 | 0.0004 |
| Lipid Particles | 0.001 | 0.0007 | 0.0072 | 0.005 | 0.0351 | 0.0013 | 0.026 | 0.0066 | 0.0278 | 0.013 | 0.0277 | 0.0123 | 0.0288 | 0.0106 | 0.0104 | 0.0651 | 0.0134 | 0.0059 |
| Mitochondria | 0.0004 | 0.0006 | 0.0005 | 0.0002 | 0.0012 | 0.0006 | 0.0116 | 0.0014 | 0.0133 | 0.0001 | 0.0085 | 0.0032 | 0.0058 | 0.0023 | 0.0003 | 0.0039 | 0.0003 | 0.0006 |
| None | 0.0062 | 0.0053 | 0.0069 | 0.0002 | 0.001 | 0.0045 | 0.0089 | 0.0049 | 0.0012 | 0.0001 | 0.04 | 0.0006 | 0.0063 | 0.0671 | 0.0015 | 0.0016 | 0.0002 | 0.0165 |
| Nuclear Periphery | 0.0436 | 0.0813 | 0.0774 | 0.0145 | 0.0299 | 0.017 | 0.093 | 0.046 | 0.0552 | 0.0046 | 0.0272 | 0.0188 | 0.0243 | 0.0746 | 0.0364 | 0.0249 | 0.0271 | 0.0201 |
| Nucleolus | 0.0964 | 0.1354 | 0.2569 | 0.4917 | 0.3285 | 0.1871 | 0.1221 | 0.162 | 0.3147 | 0.5305 | 0.3505 | 0.159 | 0.0941 | 0.207 | 0.3353 | 0.4394 | 0.3599 | 0.1703 |
| Nucleus | 0.7681 | 0.6483 | 0.4768 | 0.0868 | 0.0797 | 0.5798 | 0.54 | 0.6222 | 0.4134 | 0.1508 | 0.0708 | 0.5655 | 0.7139 | 0.5375 | 0.4778 | 0.076 | 0.143 | 0.6026 |
| Peroxisomes | 0.0001 | 0.0001 | 0.0003 | 0.0004 | 0.0055 | 0.0002 | 0.0085 | 0.0004 | 0.0088 | 0.001 | 0.0064 | 0.0054 | 0.0056 | 0.0018 | 0.0004 | 0.0093 | 0.0011 | 0.0011 |
| Punctate Nuclear | 0.0702 | 0.1042 | 0.1543 | 0.3775 | 0.2719 | 0.1945 | 0.1283 | 0.1386 | 0.0923 | 0.287 | 0.3763 | 0.1897 | 0.0792 | 0.0658 | 0.127 | 0.3428 | 0.4213 | 0.1662 |
| Vacuole | 0.001 | 0.0025 | 0.002 | 0.0018 | 0.0014 | 0.0009 | 0.0021 | 0.0021 | 0.0024 | 0.0005 | 0.0017 | 0.0012 | 0.001 | 0.0031 | 0.0012 | 0.0027 | 0.001 | 0.0014 |
| Vacuole Periphery | 0.0005 | 0.0009 | 0.0009 | 0.0004 | 0.0008 | 0.0003 | 0.0024 | 0.0009 | 0.0016 | 0.0001 | 0.0015 | 0.001 | 0.0008 | 0.0013 | 0.0005 | 0.0037 | 0.0002 | 0.0008 |
Sequencing Data
| R1 | R2 | |||||||||
|---|---|---|---|---|---|---|---|---|---|---|
| G1 Post-START | S/G2 | Metaphase | Anaphase | Telophase | G1 Post-START | S/G2 | Metaphase | Anaphase | Telophase | |
| Gene Expression | 27.4992 | 16.2022 | 12.4373 | 15.3006 | 10.9393 | 14.9912 | 20.2656 | 18.2055 | 14.4288 | 22.6443 |
| Translational Efficiency | 0.4913 | 0.7031 | 0.5723 | 0.4625 | 0.7435 | 0.7186 | 0.4935 | 0.3462 | 0.441 | 0.4267 |
Hit Data
| Dataset | Hit |
|---|---|
| Protein Concentration | ✔ |
| Protein Localization | ✔ |
| Gene Expression | ✘ |
| Translational Efficiency | ✘ |
Endocytosis
| Temp | Actin Patch (Sac6-tdTomato) | Cortical Patch (Sla1-GFP) | Late Endosome (Snf7-GFP) | Vacuole (Vph1-GFP) |
|---|---|---|---|---|
| 37℃ | ||||
| RT |
Cell Cycle Omics
CYCLoPs (Ycs4-GFP)
| Gene / Allele | Actin Patch (Sac6-tdTomato) | Cortical Patch (Sla1-GFP) | Late Endosome (Snf7-GFP) | Vacuole (Sac6-tdTomato) |
|---|
| Gene | Images |
|---|
| Gene | Images |
|---|
Images are not yet available
Images are not yet available